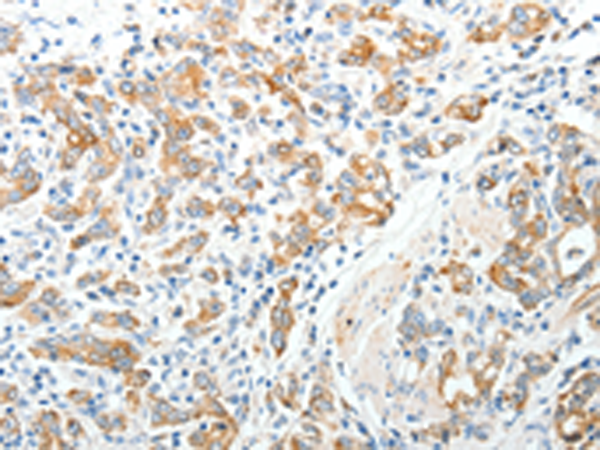

-
分类: 科研抗体货号: P11364别名:应用: IHC反应种属: Human
-
分类: 科研抗体货号: P11329别名: RPTPrho应用: IHC反应种属: Human, Mouse
-
分类: 科研抗体货号: P11348别名: EMT; EMTH; OCT3应用: WB,IHC反应种属: Human, Mouse, Rat
-
分类: 科研抗体货号: P11358别名: SPA1应用: IHC反应种属: Human
-
分类: 科研抗体货号: P11347别名: BOCT, BOIT, 24p3R, NGALR, hBOIT, NGALR2, NGALR3应用: WB,IHC反应种属: Human, Mouse, Rat
-
分类: 科研抗体货号: P11357别名: SPA, PSAP, PSPA, SP-A, SPA1, PSP-A, SFTP1, SP-A1, COLEC4, SFTPA1B应用: WB反应种属: Human, Rat
-
分类: 科研抗体货号: P11383别名: AAT5; ALK5; MSSE; SKR4; ALK-5; LDS1A; LDS2A; TGFR-1; ACVRLK4应用: IHC反应种属: Human, Mouse, Rat
-
分类: 科研抗体货号: P11355别名: HLTS应用: WB反应种属: Human, Mouse
-
分类: 科研抗体货号: P11381别名: TP1; TLP1; p240; TROVE1; VAULT2应用: IHC反应种属: Human
-
分类: 科研抗体货号: P11354别名:应用: IHC反应种属: Human, Mouse

鄂公网安备42018502007531号
鄂公网安备42018502007531号

